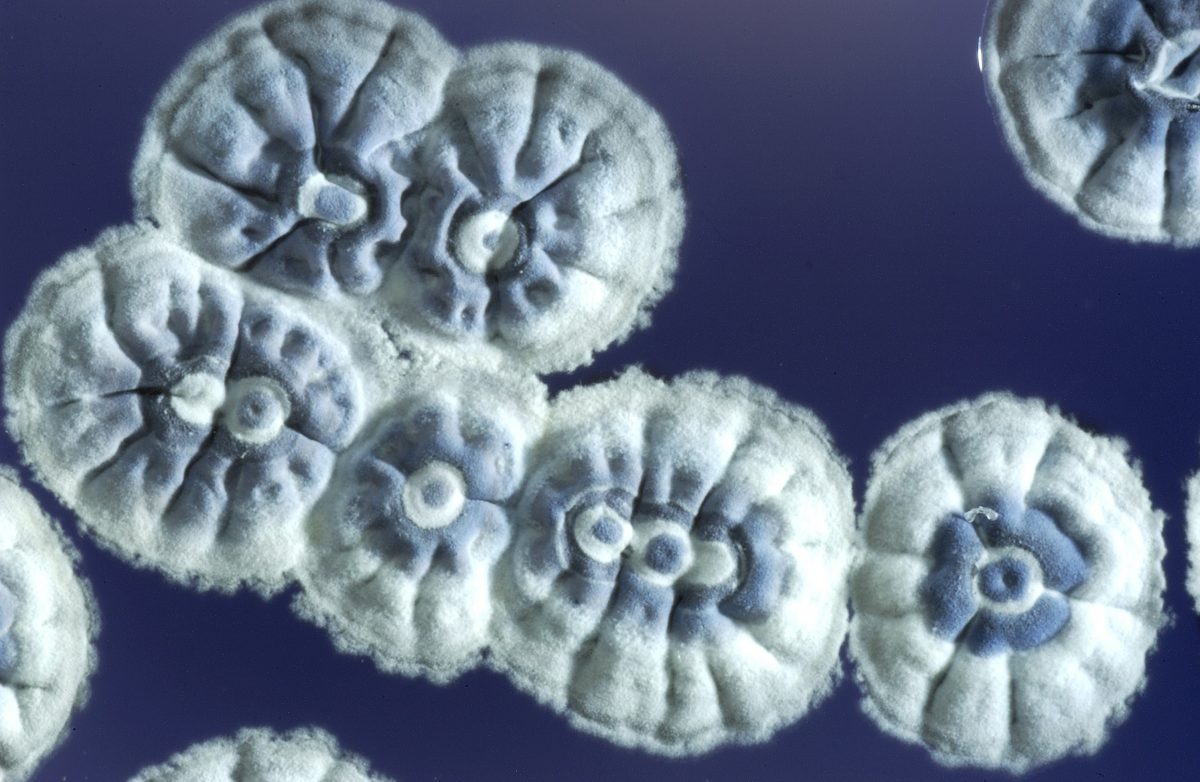

Красочные изображения бактерий Streptomyces noursei в природе

Раздел: Другие животные